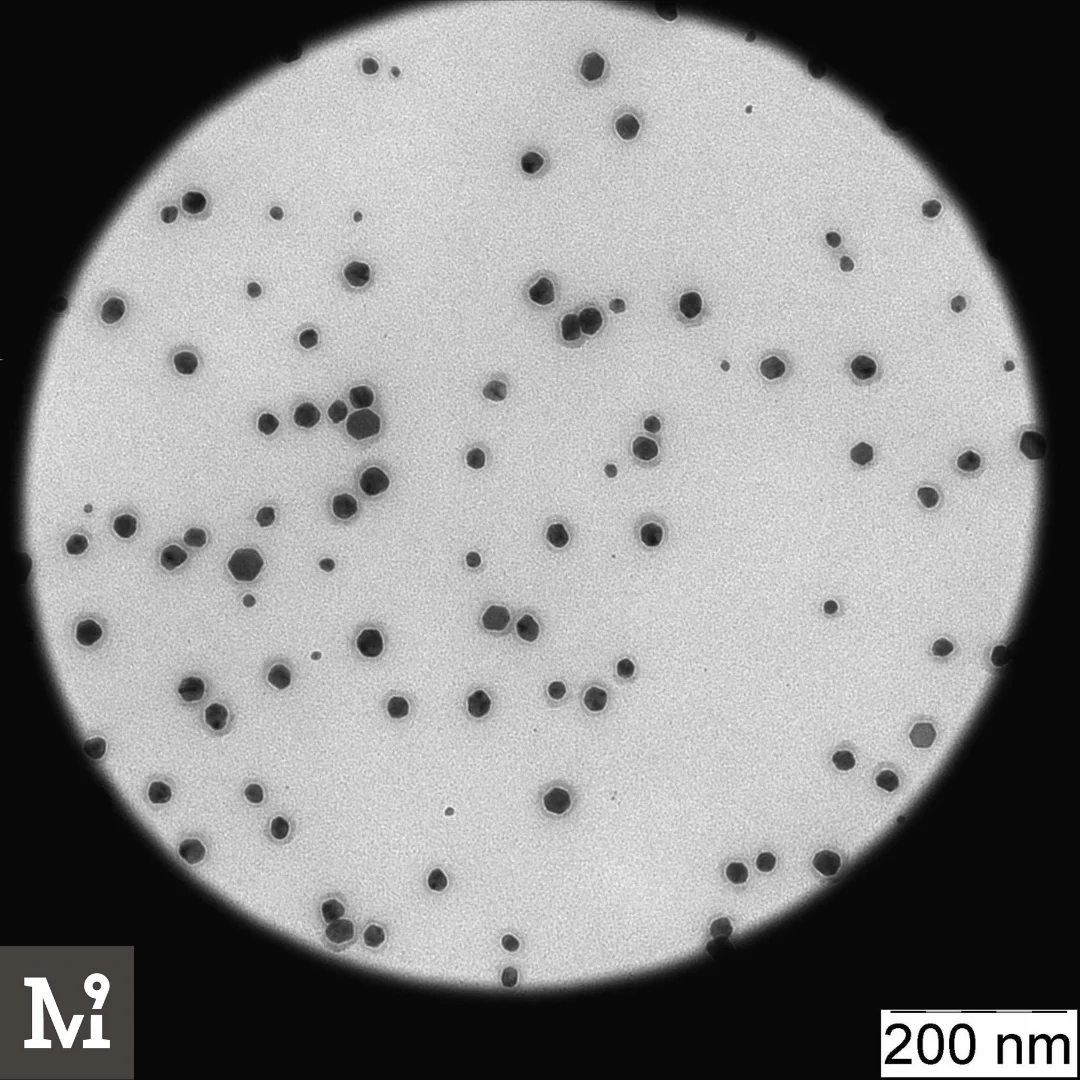
Good quality CUPRODEX 350 Liquid Copper Nanoparticle Stabilized by Cyclic Polysaccharide (b-cyclodextrin), Copper Nanoparticle

Good quality CUPRODEX 350 Liquid Copper Nanoparticle Stabilized by Cyclic Polysaccharide (b cyclodextrin), Copper Nanoparticle
- Category: >>>
- Supplier: Ninetech LLC
Share on (10000006401378):
Product Overview
Description
Copper nanoparticles in colloidal solution stabilized with Dextrine - Cuprodex 350
Properties:Fungicidal
Scope of application: cosmetics, pharmaceuticals, medicine, industry
Description:
High quality copper nanoparticle solution, stabilized by cyclic polysaccharide (b-cyclodextrin). It is used to develop cosmetic and cosmeceutical products, medical and pharmaceutical preparations. The solution is compatible with anionic, cationic and nonionic formulations. It is soluble in water. It is used for the research constructing and development in biocompatible systems.
Details:
- Particle size: 10 +- 5 nm
- Monodispersity: 65%
- Concentration: 350 ppm
- Particle shape: spherical
- Solvent: water
- Stabilizer: b-cyclodextrin
- PPR: 550 - 600 nm
- Stability pH: 6 - 10
- Solubility: water
- Thermal stability: 10 - 40 C
- Density: 1.01
- Stability: 12 months
- Storage conditions: +5 - + 35 C

Product Sample: You can order a small 50g or 100g bottle of product for quality evaluation purpose.
Sample shipping: Please note that sample shipping is paid by the buyer.
To order a sample please cotact us using Alibaba Direct Message or our contact's from Company information section in the end of product card.
Shipping method: Product can be send using Express Mail Service(EMS) or shipped using FOB, FCA(Ocean,Land,Air) or EXW(Russian Federation,Samara Region,Tolyatti city). Cargo is not dangerous and can be shiped on any transport(Air,Ocean,Land).

Packing method: Canisters, barrels, bottles or any packaging that is good for you, cargo is shipped on a pallet or in any way of configuration convenient for you.

Payment Method: You can pay for the order using a T/T, transfer to a bank card or cryptocurrencies.

1)Are you manufacture?
Yes we are manufactoring company start from 2009, our factory is located in Tolyatti city(Russian Federation, Samara Region).
2)Why should you buy from us, not from other suppliers?
- Our company has many years of experience in the production of nanomaterials with unique characteristics and properties.
- Our products have repeatedly been awarded awards at various exhibitions, including leading research centers, have a huge number of certificates and unique patented technologies.
- We have our own R&D laboratory, and our specialists have a extensive formula development experience.
- We are one of the leading company in Russia that produces certified nanomaterials.
3)What is Minimal Order Quantity(MOQ)?
The MOQ for this product is 1 liter.
4)What is your product capacity?
Product capacity of our manufactory is 1-8 tons per day.
5)How can you guarantee your quality?
We have a strict quality control system, and our specialists monitor the quality of products at all stages of production. We have been producing Ag, Cu, Au, ZnO nanoparticles since 2009, and with vast experience and knowledge in this industry, we have earned a high reputation as a supplier among our customers. We are fully confident that our product and technology will give you an undeniable advantage over your competitors in the business and great reviews from your customers.
6)In which language I can contact you?
You can contact us using English.
7)Can I get product documentation?
Yes we can provide any documentation about product by your request. Please contact us using Alibaba Direct Message or our contacts below.
8)Can I get consultation or ask any question about the product?
Yes of course, feel free to contact us using Alibaba Direct Message or our contacts below.
9)Can you help me to choose a right Silver,Gold,Copper nanoparticles solute for my product?
Yes of course, we have our own laboratory, with specialists, who can help you to choose a needed Ag,Au,Cu for your product. For consultation contact us using Alibaba Direct Message or our contacts below.
10)What currency do you accept for the order?
We can accept almost all currency.Please contact us using Alibaba Direct Message or our contacts below, to negotiate a currency you want to use, to pay for the order.
Ninetech LLC.
We are professionals in obtaining nanoparticles and creating innovative products. We embed nanoparticles into any material. We produce customized nanomaterials for scientific research and experimental development. We provide all the specifications and full technical support.
Contact Us.

Our company Partners.

Our company Office.


Our company products on exibitions.

Our company R&D Laboratory.


Our company Manufactory Zone.



We Recommend
New Arrivals
New products from manufacturers at wholesale prices